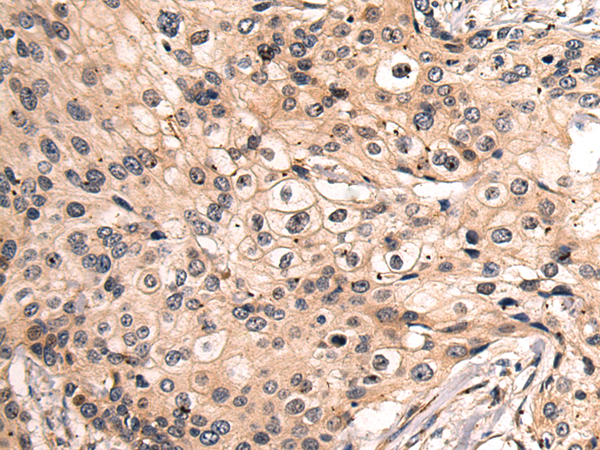
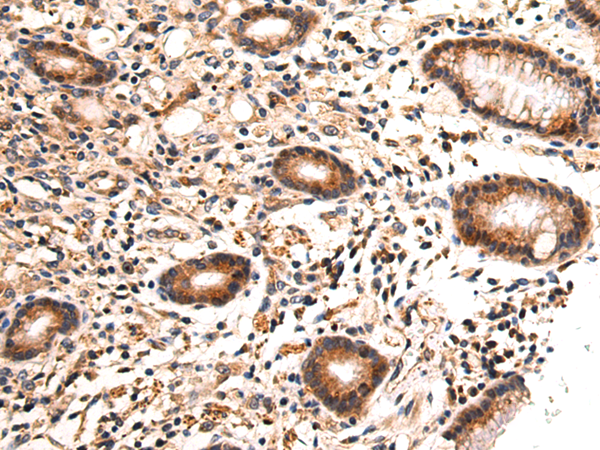

-
分类: 科研抗体货号: P10306别名: rrGTPbp; NY-MEL-1应用: WB,IHC反应种属: Human, Mouse
-
分类: 科研抗体货号: P10318别名: E25; BRI3; E25C; ITM3; BRICD2C应用: IHC反应种属: Human
-
分类: 科研抗体货号: P10299别名: SSB2; OBFC2A; SOSS-B2应用: WB,IHC反应种属: Human, Mouse, Rat
-
分类: 科研抗体货号: P10305别名: MEF-2; MST156; myEF-2; MSTP156; HsT18564应用: WB,IHC反应种属: Human
-
分类: 科研抗体货号: P10317别名: LCA14应用: WB,IHC反应种属: Human, Mouse, Rat
-
分类: 科研抗体货号: P10298别名: GIG4应用: IHC反应种属: Human, Mouse, Rat
-
分类: 科研抗体货号: P10332别名: ATR; cob; cblB; CFAP23应用: WB,IHC反应种属: Human, Mouse
-
分类: 科研抗体货号: P10316别名:应用: WB,IHC反应种属: Human, Mouse, Rat
-
分类: 科研抗体货号: P10297别名: dJ508I15.2应用: IHC反应种属: Human, Mouse, Rat
-
分类: 科研抗体货号: P10331别名: PA28A; IFI5111; REGalpha; PA28alpha; HEL-S-129m应用: IHC反应种属: Human, Mouse, Rat

鄂公网安备42018502007531号
鄂公网安备42018502007531号

